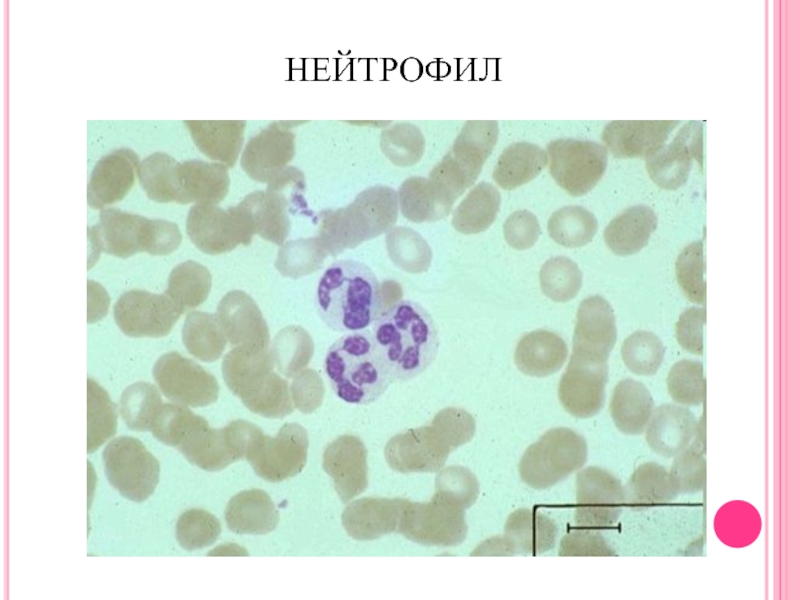
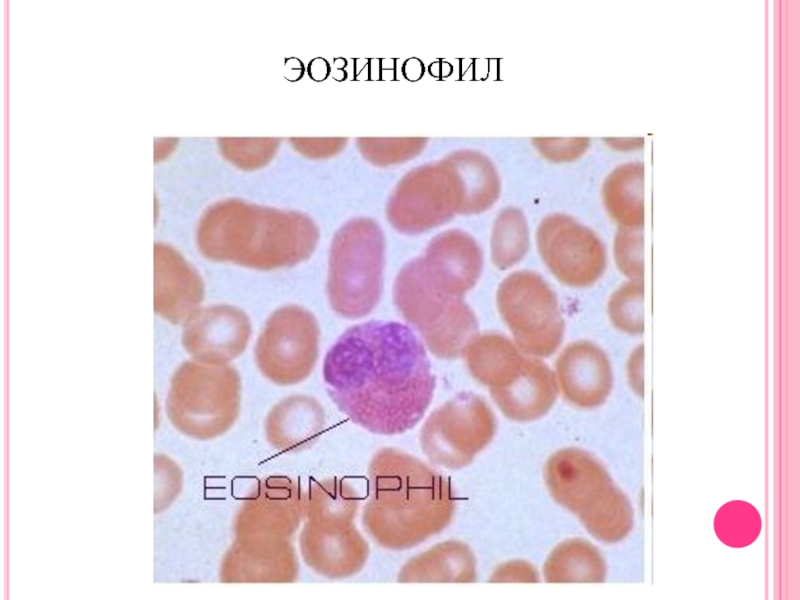
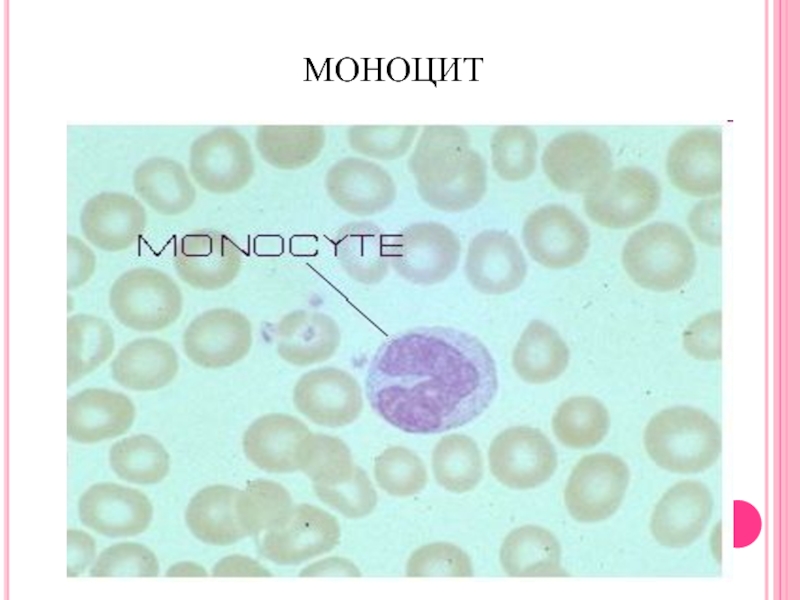

- Главная
- Разное
- Дизайн
- Бизнес и предпринимательство
- Аналитика
- Образование
- Развлечения
- Красота и здоровье
- Финансы
- Государство
- Путешествия
- Спорт
- Недвижимость
- Армия
- Графика
- Культурология
- Еда и кулинария
- Лингвистика
- Английский язык
- Астрономия
- Алгебра
- Биология
- География
- Детские презентации
- Информатика
- История
- Литература
- Маркетинг
- Математика
- Медицина
- Менеджмент
- Музыка
- МХК
- Немецкий язык
- ОБЖ
- Обществознание
- Окружающий мир
- Педагогика
- Русский язык
- Технология
- Физика
- Философия
- Химия
- Шаблоны, картинки для презентаций
- Экология
- Экономика
- Юриспруденция
Лейкоцитарлы формуланы есептеу,лейкограмманы талдау.ифт әдісі презентация
Содержание
- 1. Лейкоцитарлы формуланы есептеу,лейкограмманы талдау.ифт әдісі
- 2. ЖОСПАРЫ Кіріспе Негізгі бөлім Дәрігер-иммунологқа қаралу себептері
- 3. ДӘРІГЕР-ИММУНОЛОГҚА ҚАРАЛУ СЕБЕПТЕРІ: Жиі қайталанатын және созылмалы
- 4. ДӘРІГЕР-ИММУНОЛОГҚА ҚАРАЛУ СЕБЕПТЕРІ: Рецидивті герпевирустық инфекциялар (қарапайым
- 5. ЛЕЙКОЦИТТІК ФОРМУЛА
- 6. А*250*20 Х = ---------------А*50 100
- 7. ЕСЕПТЕУ КАМЕРАСЫ ОРТАСЫНДА 0,1 ММ ОЙЫҒЫ БАР
- 8. ӘРБІР ГОРЯЕВ ТОРЫ 225 ҮЛКЕН ТӨРТБҰРЫШТАРДАН ТҰРАДЫ,
- 9. ӘРБІР КІШІ ТӨРТБҰРЫШТА ОНЫҢ ІШІНДЕ, ТӨРТБҰРЫШТЫҢ СОЛ
- 10. АДАМНЫҢ ҚАЛЫПТЫ ЛЕЙКОЦИТТІК ФОРМУЛАСЫНЫҢ КӨРСЕТКІШТЕРІ: Б –
- 11. ЛЕЙКОЦИТТЕРДІҢ ЖАСҚА БАЙЛАНЫСТЫ КӨРСЕТКІШТЕРІ
- 12. ЛЕЙКОЦИТОЗ Физиологиялық лейкоцитоз: ауырсыну, тоңу,
- 13. ЛЕЙКОПЕНИЯ: Жүйелі қызыл жегі, ревматоидтық артрит Сульфаниламидтерді,
- 14. НЕЙТРОФИЛ
- 15. НЕЙТРОФИЛДЕРДІҢ (СЕГМЕНТТІ ЯДРОЛЫ) ЖАСҚА БАЙЛАНЫСТЫ КӨРСЕТКІШТЕРІ Таяқша ядролы нейтрофилдер: 1-5%
- 16. НЕЙТРОФИЛЕЗ (НЕЙТРОФИЛИЯ): Бактериялық, саңырауқұлақты, спирохетті, кейбір вирустық,
- 17. НЕЙТРОПЕНИЯ: Кейбір бактериялық (іш сүзегі, паратиф, бруцеллез),
- 18. ЭОЗИНОФИЛ
- 19. ЭОЗИНОФИЛДЕРДІҢ ЖАСҚА БАЙЛАНЫСТЫ КӨРСЕТКІШТЕРІ
- 20. ЭОЗИНОФИЛИЯ: Организмнің аллергиялық сенсибилизациялануы Дәрілік аллергия Тері
- 21. ЭОЗИНОПЕНИЯ: Қабыну ауруының бастапқы кезеңі Ауыр іріңді
- 22. БАЗОФИЛ – 0-1%
- 23. БАЗОФИЛИЯ: Желшешек Тағамдық және дәрілік заттарға
- 24. ЛИМФОЦИТ
- 25. ЛИМФОЦИТТЕРДІҢ ЖАСҚА БАЙЛАНЫСТЫ КӨРСЕТКІШТЕРІ
- 26. ЛИМФОЦИТОЗ: Жұқпалы аурулар: жұқпалы мононуклеоз, вирустық гепатит,
- 27. ЛИМФОПЕНИЯ: Жедел инфекциялар Милиарлы туберкулез Лимфогрануломатоз Жүйелі
- 28. МОНОЦИТ
- 29. МОНОЦИТТЕРДІҢ ЖАСҚА БАЙЛАНЫСТЫ КӨРСЕТКІШТЕРІ
- 30. МОНОЦИТОЗ: Вирустық, саңырауқұлақты, протозойлы, риккетсиозды инфециялар Грануломатоздар:
- 31. МОНОЦИТОПЕНИЯ: Апластикалық анемия (сүйек кемігінің зақымдануы) Лейкоз Пиогенді инфекциялар
- 33. НЕЙТРОФИЛ Базофил Эозинофил Лимфоцит Моноцит
- 34. ИММУНДЫҚ СТАТУС – БҰЛ ИММУНДЫҚ ЖҮЙЕ ЖАҒДАЙЫНЫҢ
- 35. ИММУНДЫҚ СТАТУСТЫ БАҒАЛАУҒА КӨРСЕТКІШТЕР: Адамның денсаулық жағдайын
- 36. ҚОРЫТЫНДЫ ЛЕЙКОГРАММАНЫ САРАПТАУ ЕРЕЖЕЛЕРІ: Лейкограмманы кешенді
- 37. ҚОЛДАНЫЛҒАН ӘДЕБИЕТТЕР «Иммунология»: Хайтов Р.М Геотамедия Мәскеу
Слайд 1ҚАРАҒАНДЫ МЕМЛЕКЕТТІК МЕДИЦИНАЛЫҚ УНИВЕРСИТЕТІ
ИММУНОЛОГИЯ ЖӘНЕ АЛЛЕРГОЛОГИЯ КАФЕДРАСЫ
ТАҚЫРЫБЫ:ЛЕЙКОЦИТАРЛЫ ФОРМУЛАНЫ ЕСЕПТЕУ,ЛЕЙКОГРАММАНЫ ТАЛДАУ.ИФТ ӘДІСІ
Орындаған:Катпина А
Көмек Д
2027 топ ЖМФ
Қарағанды 2018
Слайд 2ЖОСПАРЫ
Кіріспе
Негізгі бөлім
Дәрігер-иммунологқа қаралу себептері
Лейкоциттік формула
Иммундық статусты бағалауға көрсеткіштер
Қорытынды
Қолданылған әдебиеттер
Слайд 3ДӘРІГЕР-ИММУНОЛОГҚА ҚАРАЛУ СЕБЕПТЕРІ:
Жиі қайталанатын және созылмалы қабыну процесстері (бронхит, пневмония, жедел
Жедел қабыну ауруларының, травмалардың ұзақ жазылуы
Дене қызуының белгісіз себептермен көтерілуі (37,5 С0-тан жоғары, әлсіздік, тез шаршау, терлегіштік, сүйек және бұлшық еттердің құрысуы, буындардың ауырсынуы)
Аллергиялық аурулардың болуы
Урогениталді инфекциялар (хламидиоз, уроплазмоз, микоплазмоз, трихомониаз, т.б.)
Слайд 4ДӘРІГЕР-ИММУНОЛОГҚА ҚАРАЛУ СЕБЕПТЕРІ:
Рецидивті герпевирустық инфекциялар (қарапайым герпес, цитомегаловирустық инфекция, папиллома вирусы,
Экзематозды дерматит
Ас қорыту мүшелерінің созылмалы аурулары (жара ауруы, гастрит, холецитит, панкреатит, ішек дисбактериозы)
Жүктілік
Егде адамдарда иммундық жүйенің жұмысын жақсарту мақсатында
Слайд 5 ЛЕЙКОЦИТТІК ФОРМУЛА - ӘРТҮРЛІ ЛЕЙКОЦИТТЕРДІҢ (ЛИМФОЦИТТЕР, МОНОЦИТТЕР, НЕЙТРОФИЛДЕР, ЭОЗИНОФИЛДЕР, БАЗОФИЛДЕР) ПАЙЫЗДЫҚ
Х – 1 мкл қандағы лейкоциттер саны;
А – 100 үлкен төртбұрыштардағы лейкоциттер саны;
4000 – бір кіші төртбұрыштың көлемі;
20 – қанды араластыру дәрежесі;
1600 – лейкоциттердың саны анықталған кіші төртбұрыштардың
саны
Слайд 6
А*250*20
Х = ---------------А*50
100
Х – 1 мкл қандағы лейкоциттер саны;
а – 100
250 – бір үлкен төртбұрыштың көлемі;
20 – қанды араластыру дәрежесі;
100 – лейкоциттердың саны анықталған кіші төртбұрыштардың
саны
Слайд 7ЕСЕПТЕУ КАМЕРАСЫ ОРТАСЫНДА 0,1 ММ ОЙЫҒЫ БАР ҚАЛЫҢ ШЫНЫ ПЛАСТИНА. КАМЕРАНЫҢ
Слайд 8ӘРБІР ГОРЯЕВ ТОРЫ 225 ҮЛКЕН ТӨРТБҰРЫШТАРДАН ТҰРАДЫ, ОЛАРДЫҢ 25 ТАҒЫ ДА
Слайд 9ӘРБІР КІШІ ТӨРТБҰРЫШТА ОНЫҢ ІШІНДЕ, ТӨРТБҰРЫШТЫҢ СОЛ ЖӘНЕ ЖОҒАРЫ ШЕГАРАСЫНДА ОРНАЛАСҚАН
Слайд 10АДАМНЫҢ ҚАЛЫПТЫ ЛЕЙКОЦИТТІК ФОРМУЛАСЫНЫҢ КӨРСЕТКІШТЕРІ:
Б – базофилдер Тн – таяқша ядролы
Слайд 12
ЛЕЙКОЦИТОЗ
Физиологиялық лейкоцитоз: ауырсыну, тоңу, физикалық күш түсу, эмоциялық күш түсу, менструация,
Патологиялық
лейкоцитоз:
қабыну процестері,
жедел бактериялық және
вирустық инфекциялар,
күйік, травма, шок,
операциялар, қатерлі ісіктер,
жедел лейкоздар
Слайд 13ЛЕЙКОПЕНИЯ:
Жүйелі қызыл жегі, ревматоидтық артрит
Сульфаниламидтерді, левомицетинді, анальгетиктерді, стероидтық емес қабынуға қарсы
Иондық сәуленің әсері
Лейкоздың кейбір түрлері (жедел лейкоздың алейкемиялық кезеңі және т.б.)
Спленомегалия
Сүйек кемігінің гипо- немесе аплазиясы
Мегалобласттық анемиялар
Анафилаксиялық шок
Кахексия
Слайд 15НЕЙТРОФИЛДЕРДІҢ (СЕГМЕНТТІ ЯДРОЛЫ) ЖАСҚА БАЙЛАНЫСТЫ КӨРСЕТКІШТЕРІ
Таяқша ядролы нейтрофилдер: 1-5%
Слайд 16НЕЙТРОФИЛЕЗ (НЕЙТРОФИЛИЯ):
Бактериялық, саңырауқұлақты, спирохетті, кейбір вирустық, риккетсиозды, паразиттік инфекциялар
Қабыну процестері
Операциядан кейінгі
Ұлпалардың ишемиялық некроздалуы
Эндогенді интоксикациялар (қант диабеті, уремия, эклампсия, гепатоцитттердің некроздалуы)
Физикалық және эмоциялық күш түсу, стресс, ыстық пен суықтың әсері, ауырсыну, күйік, босану, жүктілік, қорқу, ашулану, қуану
Қатерлі ісіктер
Кейбір дәрілік заттарды қабылдау, мысалы, кортикостероидтар, гепарин, ацетилхолин
Қорғасынмен, инсектицидтермен улану
Слайд 17НЕЙТРОПЕНИЯ:
Кейбір бактериялық (іш сүзегі, паратиф, бруцеллез), вирустық (грипп, қызылша (корь), желшешек
Қан жүйесінің аурулары
Гиперспленизм
Туа біткен нейтропения
Чедиак-Хигаси синдромы
Дәрілік нейтропения
Слайд 20ЭОЗИНОФИЛИЯ:
Организмнің аллергиялық сенсибилизациялануы
Дәрілік аллергия
Тері аурулар (экзема, герпес тәрізді дерматит)
Паразиттік инвазиялар (лямблиоз,
Жұқпалы аурулардың жедел кезеңі (скарлатина, желшешек, туберкулез, жұқпалы мононуклеоз, гонорея)
Қатерлі ісіктер (әсіресе метастаздалған және некроздалған).
Қан түзу жүйесінің пролиферативті аурулары (лимфогрануломатоз, миелопролиферативті аурулар, спленэктомиядан кейінгі жағдай, гиперэозинофилді синдром)
Дәнекер ұлпаның қабынуы (түйінді периартериит, ревматиодтық артрит, жүйелі склеродермия)
Слайд 21ЭОЗИНОПЕНИЯ:
Қабыну ауруының бастапқы кезеңі
Ауыр іріңді инфекциялар
Шок, стресс
Әртүрлі химиялық қосындылармен, ауыр металдармен
Слайд 23
БАЗОФИЛИЯ:
Желшешек
Тағамдық және дәрілік заттарға жоғары сезімталдық
Бөгде ақуызға қарсы реакция
Нефроз
Созылмалы гемолизистік
Спленэктомиядан кейінгі жағдай
Ходжкин ауруы
Созылмалы миелолейкоз
Микседема (гипотиреоз)
Слайд 26ЛИМФОЦИТОЗ:
Жұқпалы аурулар: жұқпалы мононуклеоз, вирустық гепатит, цитомегаловирустық инфекция, көкжөтел, жедел респираторлық
Қан жүйесінің аурулары: созылмалы лимфолейкоз, лимфома
Тетрахлорэтанмен, қорғасынмен, мырышпен улану
Кейбір дәрілік заттардың әсері: леводопа, фенитоин, наркотикалық анальгетиктер
Слайд 27ЛИМФОПЕНИЯ:
Жедел инфекциялар
Милиарлы туберкулез
Лимфогрануломатоз
Жүйелі қызыл жегі
Бүйрек жетіспеушілігі
Қатерлі ісіктердің терминалді кезеңдері
Иммунтапшылықтар
Рентгенотерапия
Дәрілік заттар: хлорамбуцил,
Слайд 30МОНОЦИТОЗ:
Вирустық, саңырауқұлақты, протозойлы, риккетсиозды инфециялар
Грануломатоздар: туберкулез, сисфилис, бруцеллез, саркаидоз
Жүйелі коллагеноздар: ревматоидтық
Қан жүйесінің аурулары: созылмалы моноциттік және миеломоноциттік лейкоз, лимфогрануломатоз
Фосформен, тетрахлорэтанмен улану
Слайд 34ИММУНДЫҚ СТАТУС – БҰЛ ИММУНДЫҚ ЖҮЙЕ ЖАҒДАЙЫНЫҢ КЕШЕНДІ КӨРСЕТКІШІ, ИММУНДЫҚ ЖҮЙЕ
Слайд 35ИММУНДЫҚ СТАТУСТЫ БАҒАЛАУҒА КӨРСЕТКІШТЕР:
Адамның денсаулық жағдайын (денсаулық куәлігін) зерттеу
Иммундық жүйенің біріншілік
Жедел және созылмалы бактериялық, вирустық, паразиттік инфекциялар
Аутоиммундық ауруларды диагностикалау
Аллергиялық аурулар
Қатерлі, иммунопролиферациялық ауруларды диагностикалау
Іріңді-қабыну процестердің барысын бақылау (мониторинг)
Иммунсупрессиялық, иммуностимуляциялық терапия бақылау
Ұлпалар мен мүшелерді көшіруге донорларды таңдау және трансплантациядан кейінгі асқынуларды диагностикалау
Слайд 36
ҚОРЫТЫНДЫ
ЛЕЙКОГРАММАНЫ САРАПТАУ ЕРЕЖЕЛЕРІ:
Лейкограмманы кешенді талдау әрбір көрсеткіштерді бөлек бағалағаннан аса ақпаратты
Лейкограмманы талдау клиникалық көріністерді байқаумен бірге жүргізіледі
Иммунограмманы бір рет бағалағаннан динамикада зерттеген өте маңызды: аурудың басында, емдеу барысында және емдеу аяқталғаннан кейін
Диагностика үшін науқастың жеке денсаулық куәлігі мен өмір сүретін ортасы маңызды: радиация аймағы